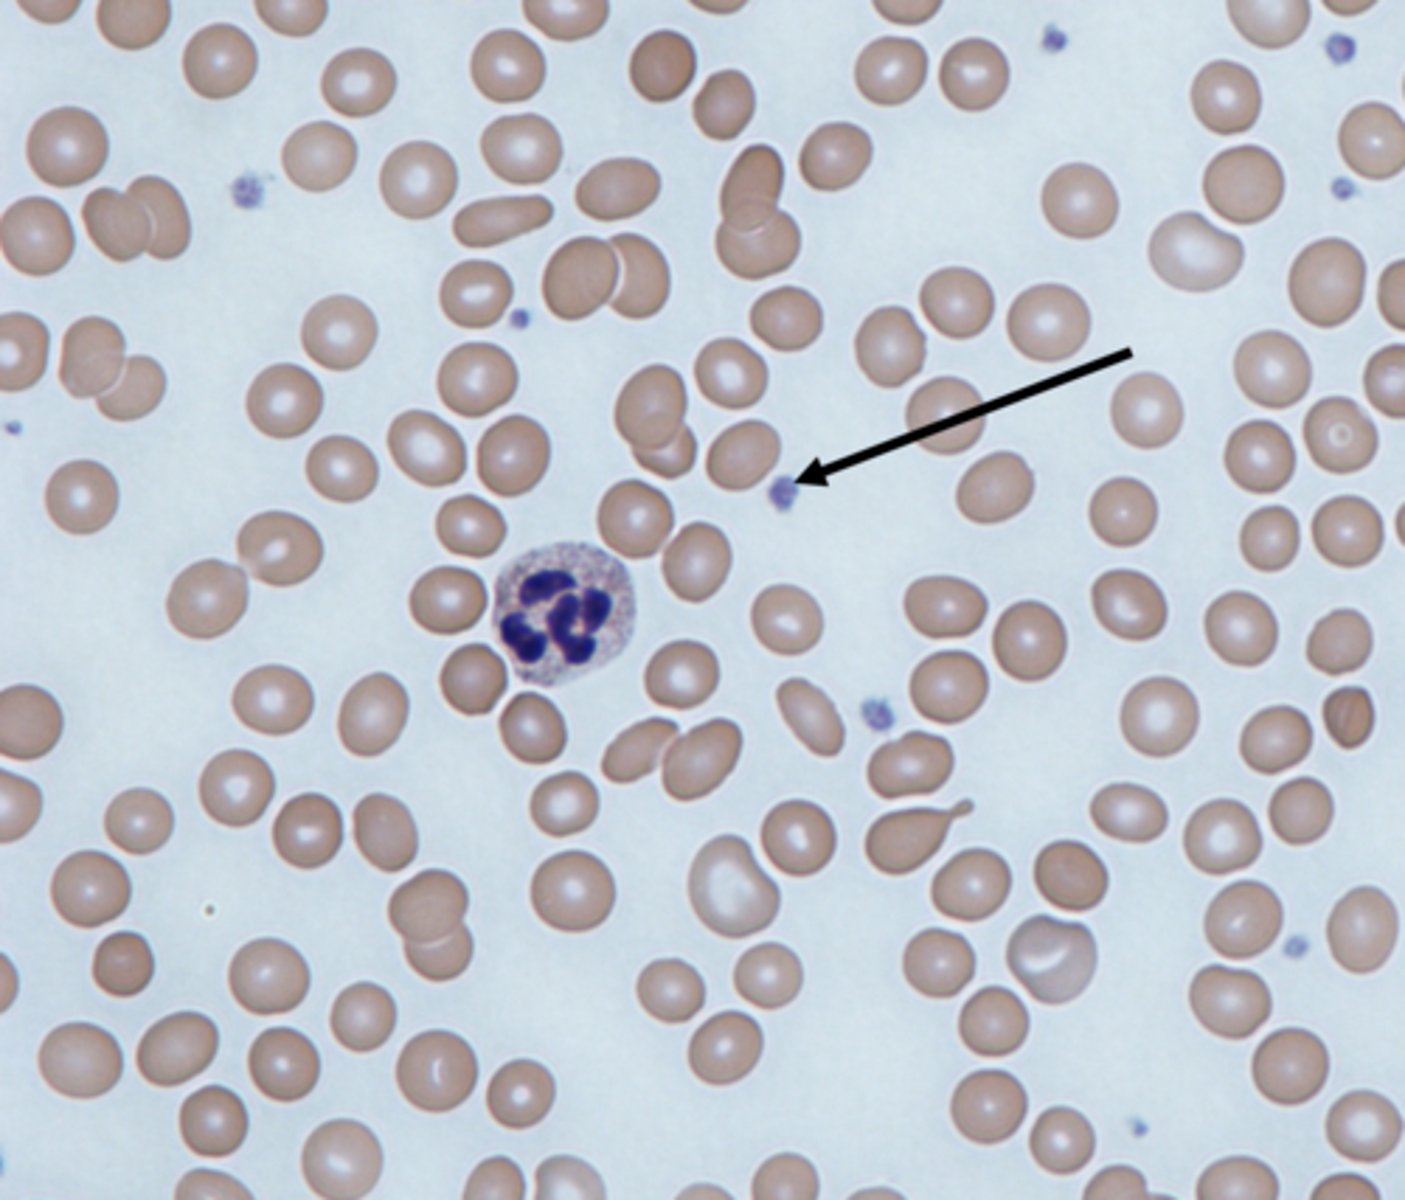
knowt flashcard image

UWEC BIO 314 Lab Exam 1
1/57
There's no tags or description
Looks like no tags are added yet.
Name | Mastery | Learn | Test | Matching | Spaced | Call with Kai |
|---|
No analytics yet
Send a link to your students to track their progress
58 Terms
Erythrocyte

Thrombocyte
Leukocyte

Granulocyte

Neutrophil

Eosinophil

Basophil

Agranulocyte

Lymphocyte

Monocyte

Red bone marrow

Megakaryocyte

Hematocrit

Polycythemia

Anemia

Antigen

Antibody

Agglutination

Epicardium

Myocardium

Endocardium

Cardiac muscle tissue

Cardiomyocyte

Intercalated disc

Atria

Left atrium

Left auricle

Right atrium

Right auricle

Left ventricle

right ventricle

Bicuspid valve

Tricuspid valve

Aortic valve

Pulmonary valve

Anterior interventricular sulcus

Posterior interventricular sulcus

Interatrial septum

Interventricular septum

Papillary muscle

Chordae tendineae

superior vena cava

Inferior vena cava

Pulmonary vein

Aortic arch

Pulmonary trunk artery

Gap junction

Left pulmonary artery

Right pulmonary artery

Coronary sinus

Great cardiac vein

Middle cardiac vein

Small cardiac vein

Left coronary artery

Circumflex artery

Anterior interventricular artery

Right coronary artery

Right marginal artery
